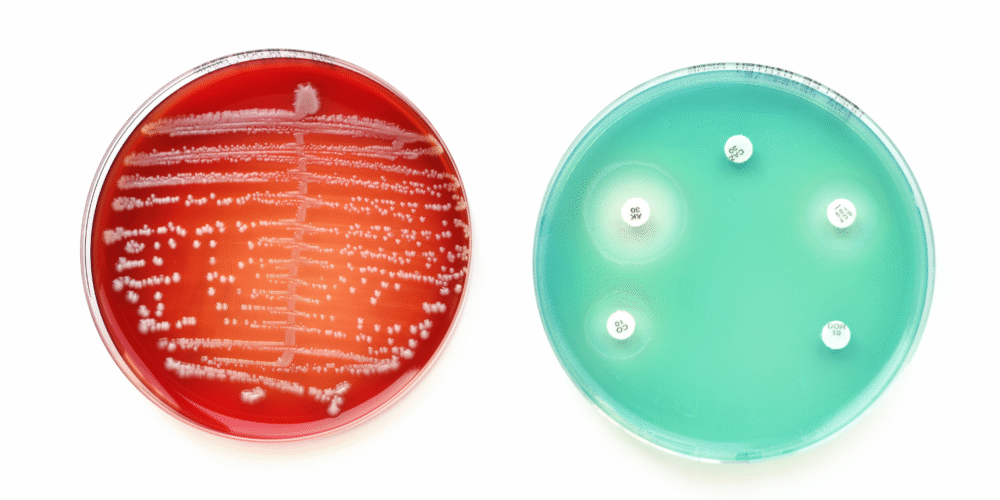

How Do I Get Tested for MRSA?
Hospital infections are a concern for many people. One of the best-known is MRSA (Methicillin-resistant Staphylococcus aureus). If you are preparing for surgery or have frequent infections, your doctor may suggest testing. But many patients ask the same question: how do I get tested for MRSA?
At Marylebone Diagnostic Centre, 73 Baker Street, London, we provide quick and discreet MRSA testing with same-day results. Here is everything you need to know.
What is MRSA?
MRSA is a type of bacteria. It is resistant to some common antibiotics, which makes it harder to treat. Not everyone with MRSA gets sick, but they can still carry it.
People most at risk include:
- Patients having surgery
- People with weakened immune systems
- Those with long-term hospital stays
- Patients using catheters or medical devices
Testing ensures carriers can be identified early and treated before problems arise.
How do you test for MRSA?
Testing is simple and painless. It usually involves a swab test. A cotton swab is rubbed inside the nose, throat, or on the skin. The swab is then sent to a laboratory to check for MRSA bacteria.
Sometimes, blood, urine, or wound samples may also be tested, especially if infection is suspected.
When should you get tested?
You may need MRSA screening if:
- You are due for surgery
- You have frequent skin infections
- You have a weak immune system
- You work in a healthcare setting
- A doctor advises testing due to risk factors
Hospitals often require an MRSA test before planned surgery to reduce the risk of complications.
How long do MRSA results take?
At MDC, results are usually available the same day. In urgent cases, we can provide results within a few hours. This ensures you can move forward with treatment or surgery without delay.
What happens if you test positive?
If MRSA is found, it does not always mean you are unwell. Many people carry MRSA on their skin or in their nose without symptoms.
Treatment often involves:
- Special antibiotic creams for the skin
- Nasal ointments to remove bacteria
- Antibacterial washes before surgery
- Targeted antibiotics if infection develops
Your doctor will explain the best approach for you.
Is MRSA testing painful?
No. The swab test is quick and causes little or no discomfort. It is similar to a COVID or throat swab.
Why choose private MRSA testing?
Choosing private testing at Marylebone Diagnostic Centre has clear benefits:
- Same-day results with no delays
- Discreet service in a calm, central London clinic
- No GP referral required
- Clear explanations from experienced clinicians
- Fast access if results are needed before surgery
Preventing MRSA
Even if you are not positive, prevention is important. Simple steps include:
- Washing hands regularly
- Keeping wounds covered
- Avoiding sharing personal items such as towels
- Cleaning medical equipment properly if used at home
FAQs about MRSA testing
Conclusion
MRSA testing is simple, fast, and vital before many medical procedures. A quick swab can make all the difference in protecting your health and the safety of others.
At Marylebone Diagnostic Centre, 73 Baker Street, London, we provide discreet and same-day MRSA testing. Whether you need results before surgery or for peace of mind, our expert team is here to help.
Book your MRSA test today at Marylebone Diagnostic Centre. Same-day results, trusted care, central London location.
73 Baker Street, London
+44 7495 970109
marylebonediagnosticcentre.com









